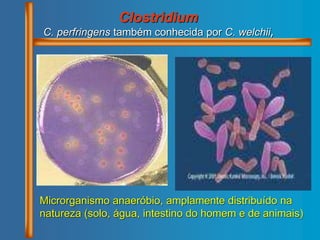
Clostridium
C. perfringens também conhecida por C. welchii,
Microrganismo anaeróbio, amplamente distribuído na
natureza (solo, água, intestino do homem e de animais)

O documento discute doenças de origem alimentar causadas por microrganismos, incluindo bactérias como Escherichia coli, Salmonella, Shigella, Vibrio, Clostridium, Listeria, Bacillus, Staphylococcus e Clostridium botulinum. Detalha sintomas, alimentos envolvidos e métodos de prevenção dessas intoxicações e infecções alimentares.